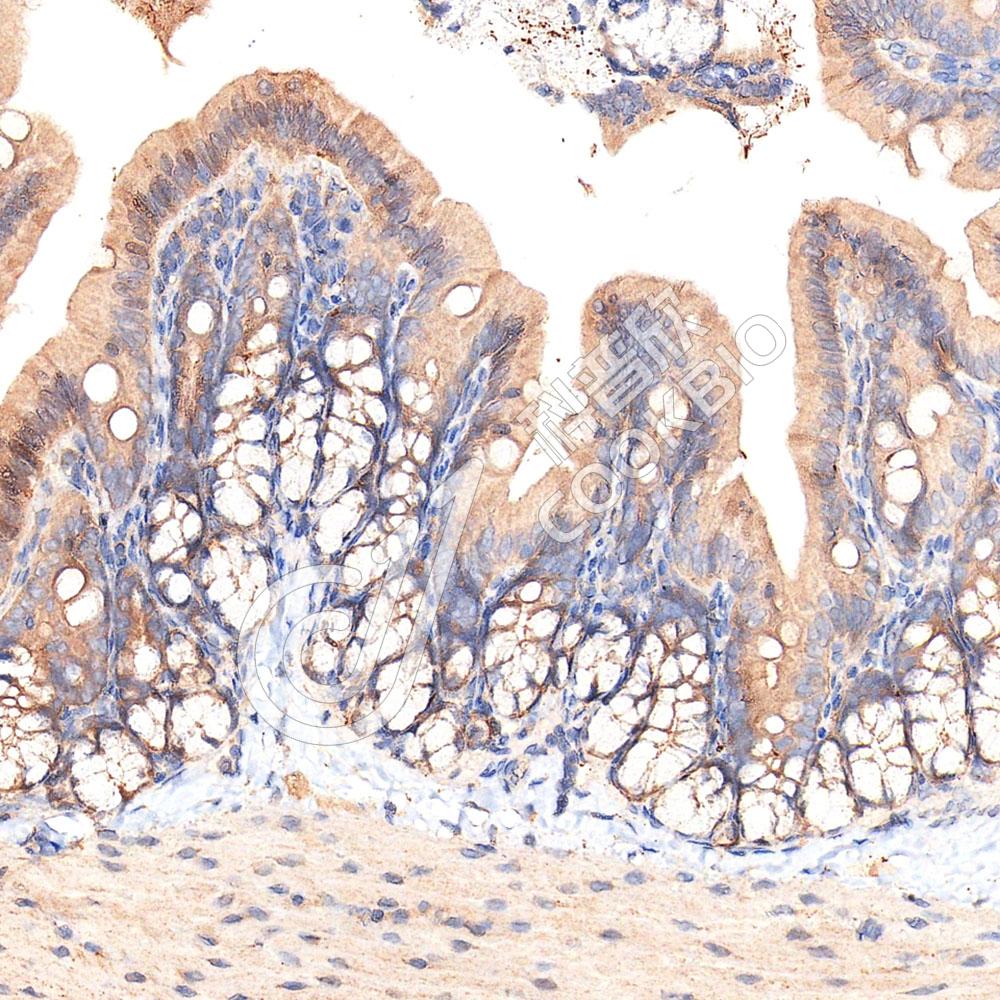

产品信息
| 蛋白质全称 | 流感病毒NS1A结合蛋白同源物 |
|---|---|
| 别名 | ARA3,FLARA3,HSPC068,IVNS1ABP,KIAA0850,ND1,NS 1,NS1,NS1 binding protein,NS1 BP,NS1BP |
| Uniprot ID | Q920Q8 |
| 免疫原 | KLH偶联的小鼠Influenza Virus NS1A Binding Protein合成肽 |
| 抗体亚型 | IgG |
| 纯化方式 | 亲和纯化 |
| 亚细胞定位 | 细胞质 |
应用
IHC/IF 免疫组织化学/免疫荧光
物种:小鼠,大鼠
稀释比:1:1200-1:3600
阳性样品:结肠
背景
Involved in many cell functions, including pre-mRNA splicing, the aryl hydrocarbon receptor (AHR) pathway, F-actin organization and protein ubiquitination. Plays a role in the dynamic organization of the actin skeleton as a stabilizer of actin filaments by association with F-actin through Kelch repeats. Protects cells from cell death induced by actin destabilization. Functions as modifier of the AHR/Aryl hydrocarbon receptor pathway increasing the concentration of AHR available to activate transcription. In addition, functions as a negative regulator of BCR(KLHL20) E3 ubiquitin ligase complex to prevent ubiquitin-mediated proteolysis of PML and DAPK1, two tumor suppressors. Inhibits pre-mRNA splicing (in vitro).; [Isoform 2]: May play a role in cell cycle progression in the nucleus.
储存条件
储存条件:储存条件在:-20℃下储存一年, 避免反复冻融.
储存缓冲液:含0.15% ProClin300防腐剂, 100 μg/mL牛血清白蛋白和50%甘油的磷酸盐缓冲液.
图像

IHC检测Influenza Virus NS1A Binding Protein蛋白(货号 K1344832).
样品: 小鼠结肠, 4%多聚甲醛 (货号KSG1101) 固定12-24小时.
抗原修复: Tris-EDTA抗原修复液(pH 9.0) (KSG1203), 98℃, 20分钟.
—抗: 1: 2400稀释, 4℃ 孵育过夜.
二抗: S-vision免疫组化多聚二抗(山羊抗兔),即用型 (货号KB3906), 室温孵育20分钟.
样品: 小鼠结肠, 4%多聚甲醛 (货号KSG1101) 固定12-24小时.
抗原修复: Tris-EDTA抗原修复液(pH 9.0) (KSG1203), 98℃, 20分钟.
—抗: 1: 2400稀释, 4℃ 孵育过夜.
二抗: S-vision免疫组化多聚二抗(山羊抗兔),即用型 (货号KB3906), 室温孵育20分钟.
IHC检测Influenza Virus NS1A Binding Protein蛋白(货号 K1344832).
样品: 大鼠结肠, 4%多聚甲醛 (货号KSG1101) 固定12-24小时.
抗原修复: Tris-EDTA抗原修复液(pH 9.0) (KSG1203), 98℃, 20分钟.
—抗: 1: 2400稀释, 4℃ 孵育过夜.
二抗: S-vision免疫组化多聚二抗(山羊抗兔),即用型 (货号KB3906), 室温孵育20分钟.
样品: 大鼠结肠, 4%多聚甲醛 (货号KSG1101) 固定12-24小时.
抗原修复: Tris-EDTA抗原修复液(pH 9.0) (KSG1203), 98℃, 20分钟.
—抗: 1: 2400稀释, 4℃ 孵育过夜.
二抗: S-vision免疫组化多聚二抗(山羊抗兔),即用型 (货号KB3906), 室温孵育20分钟.
需要技术支持?
如果您有任何问题或如果您在实验过程中遇到问题,或需要更详细的技术指导,请联系我们的技术支持团队
 400-6027-270
400-6027-270
联系我们
如果您对我们的公司或产品有任何疑问,欢迎随时联系我们





















 湖北省武汉市东湖新技术开发区高新二路388号生物医药加速器22栋5楼
湖北省武汉市东湖新技术开发区高新二路388号生物医药加速器22栋5楼  400-6027-270
400-6027-270  鄂公网安备42018502008544号
鄂公网安备42018502008544号